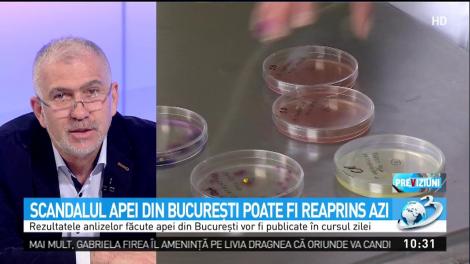
Scandalul apei din Bucureşti poate fi reaprins azi

Prognoza meteo 8 februarie 2019. Administrația Națională de Meteorologie(ANM) a emis o avertizare de tip Cog Galben pentru două județe din țară. Citește previziunile meteo complete pentru ziua de astăzi.
Vineri, 08.02.2019, 08:08
Vremea 8 februarie 2019. Potrivit meteorologilor, ziua de vineri se anunta una deosebit de frumoasa cu temperaturi mai ridicate in comparație cu ziua precedenta. Citeste prognoza meteo completa pentru ziua de vineri, 8 februarie.
Vineri, 08.02.2019, 08:06
Peste 3500 de spectatori de toate vârstele s-au bucurat, în prima reprezentaţie, de cele mai îndrăgite poveşti. Mickey Mouse şi prietenii săi sunt gazdele producţiei care a încântat peste 285 de milioane de oameni din 67 de țări. Show-ul...
Vineri, 08.02.2019, 07:57
Direcţia de Sănătate Publică a Municipiului Bucureşti (DSPMB) a înfiinţat, joi, o linie telefonică directă pentru obţinerea de informaţii despre serviciile medicale acordate de Matteo Politi în clinici private din capitală. Numărul de telefon va fi valabil până în 15 februarie.
Joi, 07.02.2019, 19:53
UPDATE. Bărbatul care s-a aruncat în fața metroului la stația Gorjului din București a fost declarat mort.
Joi, 07.02.2019, 12:05
După succesul înregistrat anul trecut de recitalurile artiștilor latino Maluma și Luis Fonsi, festivalul El Carrusel revine și în 2019, în perioada 27-30 iunie, la Romexpo. Ediția de anul acesta îi are cap de afiș pe J Balvin, Nicky Jam și Ozuna, unii dintre cei mai apreciați artiști raggaeton ai momentului.
Joi, 07.02.2019, 11:31
Transport gratuit în București. Cine beneficiază de abonament gratuit STB și de când.
Joi, 07.02.2019, 10:50
Evenimente București 8 februarie 2019
Joi, 07.02.2019, 10:40
Organizatorii concertului pe care Ed Sheeran îl va susține pe Arena Națională din București, pe 3 iulie 2019, au anunțat că James Bay și Zara Larsson sunt artiștii care vor cânta în deschiderea spectacolului artistului britanic.
Joi, 07.02.2019, 09:56
Prognoza meteo. Când vin ninsorile! Vremea se schimbă radical în următoarea perioadă, cu temperaturi scăzute și ninsori, în principal la munte.
Joi, 07.02.2019, 09:33
Românii pot beneficia de un ajutor de la stat de 2.500 de lei, în cazul în care au copii nou-născuți, una dintre condiții fiind ca măcar unul dintre părinți să aibă domiciul sau reşedinţa în Bucureşti.
Joi, 07.02.2019, 08:27
Meteo 7 februarie 2019. Potrivit meteorologilor, vor cadea ploi slabe local, iar izolat precipitatiile se vor transforma in lapovita. Citeste prognoza meteo completa pentru ziua de joi.
Joi, 07.02.2019, 08:06
Italianul acuzat că a operat în mai multe clinici private din București, deşi are doar opt clase absolvite, a fost prins în timp ce încerca să fugă din țară. Poliţiştii de frontieră l-au găsit într-un tren, la punctul de frontieră de la Curtici.
Miercuri, 06.02.2019, 22:50
Alţi doi bărbaţi, din judeţul Prahova şi din municipiul Bucureşti, au murit, miercuri, din cauza gripei, ambii având şi alte afecţiuni şi nefiind vaccinaţi anti-gripal. Numărul deceselor cauzate de gripă în acest sezon ajunge astfel la 91
Miercuri, 06.02.2019, 21:40
Matteo Politi, italianul acuzat că a operat în mai multe clinici private din București, deşi avea doar opt clase, a fost adus, miercuri seară, de către polițiști, pentru a fi audiat la Secția 4 de Poliție din Capitală.
Miercuri, 06.02.2019, 21:30
ANM, estimari temperaturi 7-13 februarie. Prognoza meteo pentru urmatoarea perioada anunta temperaturi in crestere pentru majoritatea regiunilor. Afla de ce temperaturi vom avea parte in perioada mentionata.
Miercuri, 06.02.2019, 20:49
Imaginiile aducerii la București a pretinsului doctor.
Miercuri, 06.02.2019, 19:22
Liviu Dragnea: Nu ia nimeni din banii pentru București
Miercuri, 06.02.2019, 18:17
Vremea in Bucuresti 7 februarie 2019. Potrivit meteorologilor, temperaturile in Capitala vor scadea sintitor in special pe pe timpul nopții(pana spre -2 grade). Veremea in Capitala joi.
Miercuri, 06.02.2019, 18:14
Meteo 6 februarie 2019. Administratia Nationala de Meteorologie(ANM) a emis avertizari, de tip Cod Galben, de vreme severa pentru urmatoarele ore. Afla cum va evolua vremea, prognoza meteo completa.
Miercuri, 06.02.2019, 17:05
Vremea 7 februarie 2019. Prognoza meteo pentru ziua de joi anunta precipitatii sub forma de lapovita pe arii restranse. Afla cum va fi vremea in Bucuresti si unde se vor semnala precipitatiile insemnate cantitativ.
Miercuri, 06.02.2019, 16:50
Primarul general al Capitalei, Gabriela Firea, a dezvăluit în această după amiază care sunt planurile sale din punct de vedere politic.
Miercuri, 06.02.2019, 16:25
De câţiva ani, bărbaţii cei mai potenţi financiari din lume şi-au creat un obicei din a veni în România să-şi extindă business-urile. Dar, mai ales pentru a impresiona sexul frumos de la noi cu bogăţiile pe care le deţin. Aşa a făcut...
Miercuri, 06.02.2019, 14:36
Maşinile de lux au rămas doar un vis frumos pentru vedetele concurente la „Asia Express”. Starurile au fost nevoite să renunţe la pretenţii şi să circule cu mijloace de transport care mai de care mai ciudate.

Matteo Politi, falsul doctor italian cu numai opt clase absolvite, care a operat zeci de oameni în clinici de top din Bucureşti, a fost prins de poliţişti într-un tren, în vama Curtici. Doctorul fals Politi va fi predat autorităților.
Miercuri, 06.02.2019, 10:50
Funcționarea Direcției de Sănătate Publică București care i-a eliberat codul de parafă medicului italian fals a dat o explicație de necrezut pentru decizia ei, în urma căreia medicul escroc Matteo Politi a operat la mai multe clinici private din România.
Miercuri, 06.02.2019, 10:43
„Nu a fost înregistrată nicio reclamaţie în cazul medicului fals lui Matteo Politi, la Colegiul Medicilor din Municipiul Bucureşti (CMMB), nici de la medicul estetician care a declarat în mass media că a făcut acest lucru, şi nici de la vreo altă persoană”, au precizat reprezentanţii Colegiului Medicilor Bucureşti.
Miercuri, 06.02.2019, 10:00
Invitați la "Neatza cu Răzvan și Dani", Quantum Robotics, echipa de robotică a Liceului Internațional de Informatică București, a adus robotul câștigător de la Campionatul de Robotică din Coreea de Sud.

O țară întreagă este revoltată de cazul italianului cu opt clase care a venit în România și a operat zeci de pacienți din patru clinici din București.
Miercuri, 06.02.2019, 09:29
Evenimente București 7 februarie 2019
Miercuri, 06.02.2019, 09:00
Vremea 6 februarie 2019. Prognoza meteo pentru miercuri anunta prezența unui ciclon mediteranean slab dezvoltat ce vor aduce unele ploi slabe trecatoare in sudul extrem al teritoriului.
Miercuri, 06.02.2019, 08:40
Un tânăr în vârstă de 21 de ani, din Buftea, a fost împușcat de polițiștii din Ilfov și a ajuns de urgență la un spital din București. Oamenii legii au tras mai multe focuri de armă, în plan vertical şi orizontal, pentru prinderea a trei tineri care se aflau într-o maşină ce nu a oprit la semnalele patrulei.
Miercuri, 06.02.2019, 07:56
Atenție, șoferi! Hoții români au găsit o nouă metodă de a face bani folosind o înșelătorie ce produce pagube uriașe victimelor.
Marti, 05.02.2019, 21:59
Pentru combustibilul din rezervor, o bandă de hoţi pune vieţi în pericol. Indivizii taie noaptea rezervoarele şi pot lăsa dezastru în urmă dacă benzina ia foc. Ultimul caz a fost înregistrat în Capitală.
Marti, 05.02.2019, 19:17
Autobuzele din Capitală, dar şi din alte oraşe ale ţării nu mai fac curse fără să fie dezinfectate cu atenţie înainte.
Marti, 05.02.2019, 18:48
Vremea in Bucuresti 6 februarie 2019. Potrivit meteorologilor, in Capitala, cerul va fi acoperit de nori iar temperaturile vor cobora simtitor. Vremea in Capitala miercuri.
Marti, 05.02.2019, 18:08
Meteo 6 februarie 2019. Prognoza meteo anunta temperaturi in scadere. Vremea se schimba radical pe parcursul zilei de miercuri. Citeste prognoza meteo completa pentru aceasta zi.
Marti, 05.02.2019, 17:31
Poliţiştii şi procurorii din Ilfov cer sprijinul populaţiei într-un dosar deschis după ce trupul însufleţit al unui bebeluş a fost găsit la o staţie de sortare a deşeurilor, la finalul lunii decembrie.
Marti, 05.02.2019, 16:45
Amatorii de festivaluri au un nou motiv de bucurie! Palatul Mogoșoaia va fi gazda festivalului Fall in Love, ce va avea loc între 31 august și 1 septembrie și îi va reuni pe aceeași scenă pe Liam Gallagher, Disclosure (DJ Set), Kaiser Chiefs și Kovacs.
Marti, 05.02.2019, 15:05
Evenimente București 6 februarie 2019
Marti, 05.02.2019, 12:37
Ministrul Sănătății, Sorina Pintea, a reacționat imediat după ce s-a aflat de cazul italianului cu doar opt clase care a ajuns să opere pacienți de la patru clinici din București.
Marti, 05.02.2019, 11:16
Conform specialiștilor NASA, un asterodid de 40 de metri diametru poate lovi Terra, pe 9 septembrie, la ora 10:03, cu peste 44 de kilometri pe oră. Din cele 816 corpuri cerești ce amenință Pământul, acesta este cel de-al șaptele pericol real ca iminență. În caz de impact, poate ”rade” Bucureștiul și Județul Ilfov. Traiectoria clară va putea fi aflată abia în luna iulie cu un telescop de opt metri
Marti, 05.02.2019, 10:31
Părinții unei fetițe din Capitală sunt disperați după ce micuța a dispărut de acasă, motiv pentru care fac apel la oameni ca oricine o vede să sune la Poliție.
Marti, 05.02.2019, 10:12
Conform ”Libertatea”, de un an de zile, cu aviz oficial, un medic fals italian, ”specialist” în chirurgie plastică, operează la cinci clinci din București!!! Hoţul de identitate, devenit doctor fără să facă liceul, şi-a bătut joc de pacienţi şi spitale timp de doi ani”, titra La Stampa, în septembrie 2010.
Marti, 05.02.2019, 08:40
Caz șocant petrecut în Sectorul 3 din București! Un bărbat fără frica lui Dumnezeu a pătruns într-o biserică în mod ilegal și a comis o faptă de-a dreptul scandaloasă! Ce a făcut omul în lăcașul sfânt?
Luni, 04.02.2019, 23:16
Un incendiu a izbucnit, luni, la un depozit dezafectat de pe Şoseaua de Centură a Capitalei, între Bragadiru şi Domneşti. Mai multe autospeciale s-au deplasat la fața locului pentru a interveni!
Luni, 04.02.2019, 17:09
Ministrul Apelor și Pădurilor, Ioan Deneş, a declarat, luni, într-o conferinţă de presă, că în spaţiul public anumite persoane au continuat să acuze Apele Române în legătură cu calitatea apei potabile din Bucureşti.
Luni, 04.02.2019, 16:56
Vremea in Bucuresti 5 februarie 2019. Meteorologii anunta temperaturi care se vor incadra intre 8°C si -1°C in Capitala. Citeste prognoza meteo completa pentru ziua de marti.
Luni, 04.02.2019, 16:12
Meteo 5 februarie 2019. Cum va fi vremea marți în București
Luni, 04.02.2019, 15:53